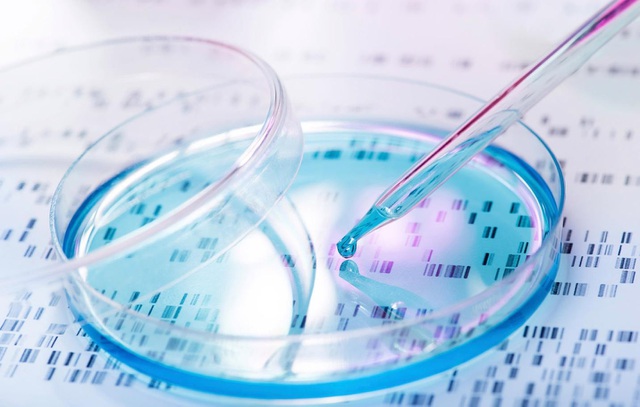

Hệ thống chỉnh sửa gene mới có thể xóa sổ nhiều loại ung thư
TNNN - Theo tiết lộ mới nhất, các nhà khoa học đang phát triển một hệ thống mới sử dụng hệ thống chỉnh sửa bộ gene CRISPR để tấn công và tiêu diệt tế bào ung thư.
Các thử nghiệm và thử nghiệm bổ sung là cần thiết, nhưng hệ thống mới đầy hứa hẹn cuối cùng có thể được sử dụng để chống lại bệnh ung thư ở người.
Cuộc chiến chống lại bệnh ung thư đã và đang tiếp diễn kể từ khi các bác sĩ nhận ra rằng căn bệnh này gây chết người. Đã có nhiều tiến bộ trong cuộc chiến chống lại căn bệnh ung thư, mặc dù các phương pháp chữa trị thực sự dường như luôn nằm ngoài tầm với.
Để giải quyết bài toán nan giải với căn bệnh ung thư quái ác, các nhà nghiên cứu tại Đại học Tel Aviv tin rằng họ đang tiến tới mục tiêu đáng kinh ngạc hơn đó là nhờ sự trợ giúp của hệ thống chỉnh sửa bộ gene CRISPR.
Các nhà khoa học đã giải thích trên tạp chí Science Advances rằng công cụ được phát triển với hy vọng điều chỉnh các lỗi di truyền có hại tiềm ẩn có thể chứng minh là công cụ cuối cùng để tiêu diệt các bệnh ung thư chết người.
Nghiên cứu của nhóm đã tiết lộ rằng họ sử dụng "hệ thống phân phối dựa trên hạt nano lipid mới", có thể nhắm mục tiêu các tế bào ung thư một cách cụ thể và tiêu diệt chúng hiệu quả mà không có cơ hội kích hoạt lại.
Các nhà khoa học tiết lộ đã sử dụng công nghệ CRISPR Cas9 để nhắm mục tiêu vào các tế bào ung thư và hoạt động như một "chiếc kéo phân tử" để cắt đứt DNA của tế bào, giết chết nó.
Cụ thể hơn, các nhà nghiên cứu đã tìm cách chứng minh rằng hệ thống này hoạt động bằng cách nhắm vào khối u nguyên bào thần kinh đệm và ung thư buồng trứng di căn, là hai trong số những bệnh ung thư có tỷ lệ tử vong cao nhất. Chúng nổi tiếng là những căn bệnh ung thư đã cướp đi sinh mạng của rất nhiều người mỗi năm. Khi nhắm mục tiêu những bệnh ung thư này ở chuột, một lần điều trị duy nhất với hệ thống CRISPR mới đã làm tăng gấp đôi tỷ lệ sống sót của động vật. Đó là chỉ sau một đợt điều trị, điều này thật đáng kinh ngạc.
Giáo sư Dan Peer, đồng tác giả của nghiên cứu, cho biết trong một tuyên bố: "Đây là nghiên cứu đầu tiên trên thế giới chứng minh rằng hệ thống chỉnh sửa bộ gene CRISPR có thể được sử dụng để điều trị ung thư hiệu quả ở động vật sống. Cần phải nhấn mạnh rằng đây không phải là hóa trị. Không có tác dụng phụ và tế bào ung thư được điều trị theo cách này sẽ không bao giờ hoạt động trở lại. Chiếc kéo phân tử của Cas9 cắt DNA của tế bào ung thư, do đó vô hiệu hóa nó và ngăn chặn vĩnh viễn sự nhân lên".
Trong tương lai, các nhà nghiên cứu muốn thử giải quyết các loại bệnh khác, bao gồm ung thư máu và các bệnh di truyền để xem hệ thống chỉnh sửa gene có thể tạo ra sự khác biệt ra sao.
Nếu các thử nghiệm tỏ ra hứa hẹn, chúng ta có thể sớm thấy CRISPR được sử dụng cho nhiều loại bệnh, thậm chí có thể là một công cụ đầy hứa hẹn để xóa sổ nhiều loại ung thư.
Nguồn: Dân Trí


Gợi mở về vai trò của diêm tiêu Việt Nam trong lịch sử thế giới

Thiết kế pin mới giúp giảm nguy cơ cháy nổ

JASIS 2025 – Triển lãm thiết bị khoa học và phân tích hàng đầu châu Á

Cấp thiết sửa đổi quy chuẩn kỹ thuật quốc gia cho sản phẩm sữa chế biến

Kiểm tra, xác nhận giá trị sử dụng phương pháp; ước lượng độ không đảm bảo đo lĩnh vực sinh học

Đảm bảo chất lượng kết quả thử nghiệm

Nhận thức chung ISO/IEC 17025:2017 và đánh giá nội bộ

Xác nhận giá trị sử dụng phương pháp thử trong phân tích hóa học

Triệt để tránh tình trạng “dễ làm, khó bỏ” trong nghiên cứu khoa học

Báo động: Vi nhựa xâm nhập não người với tốc độ nhanh













